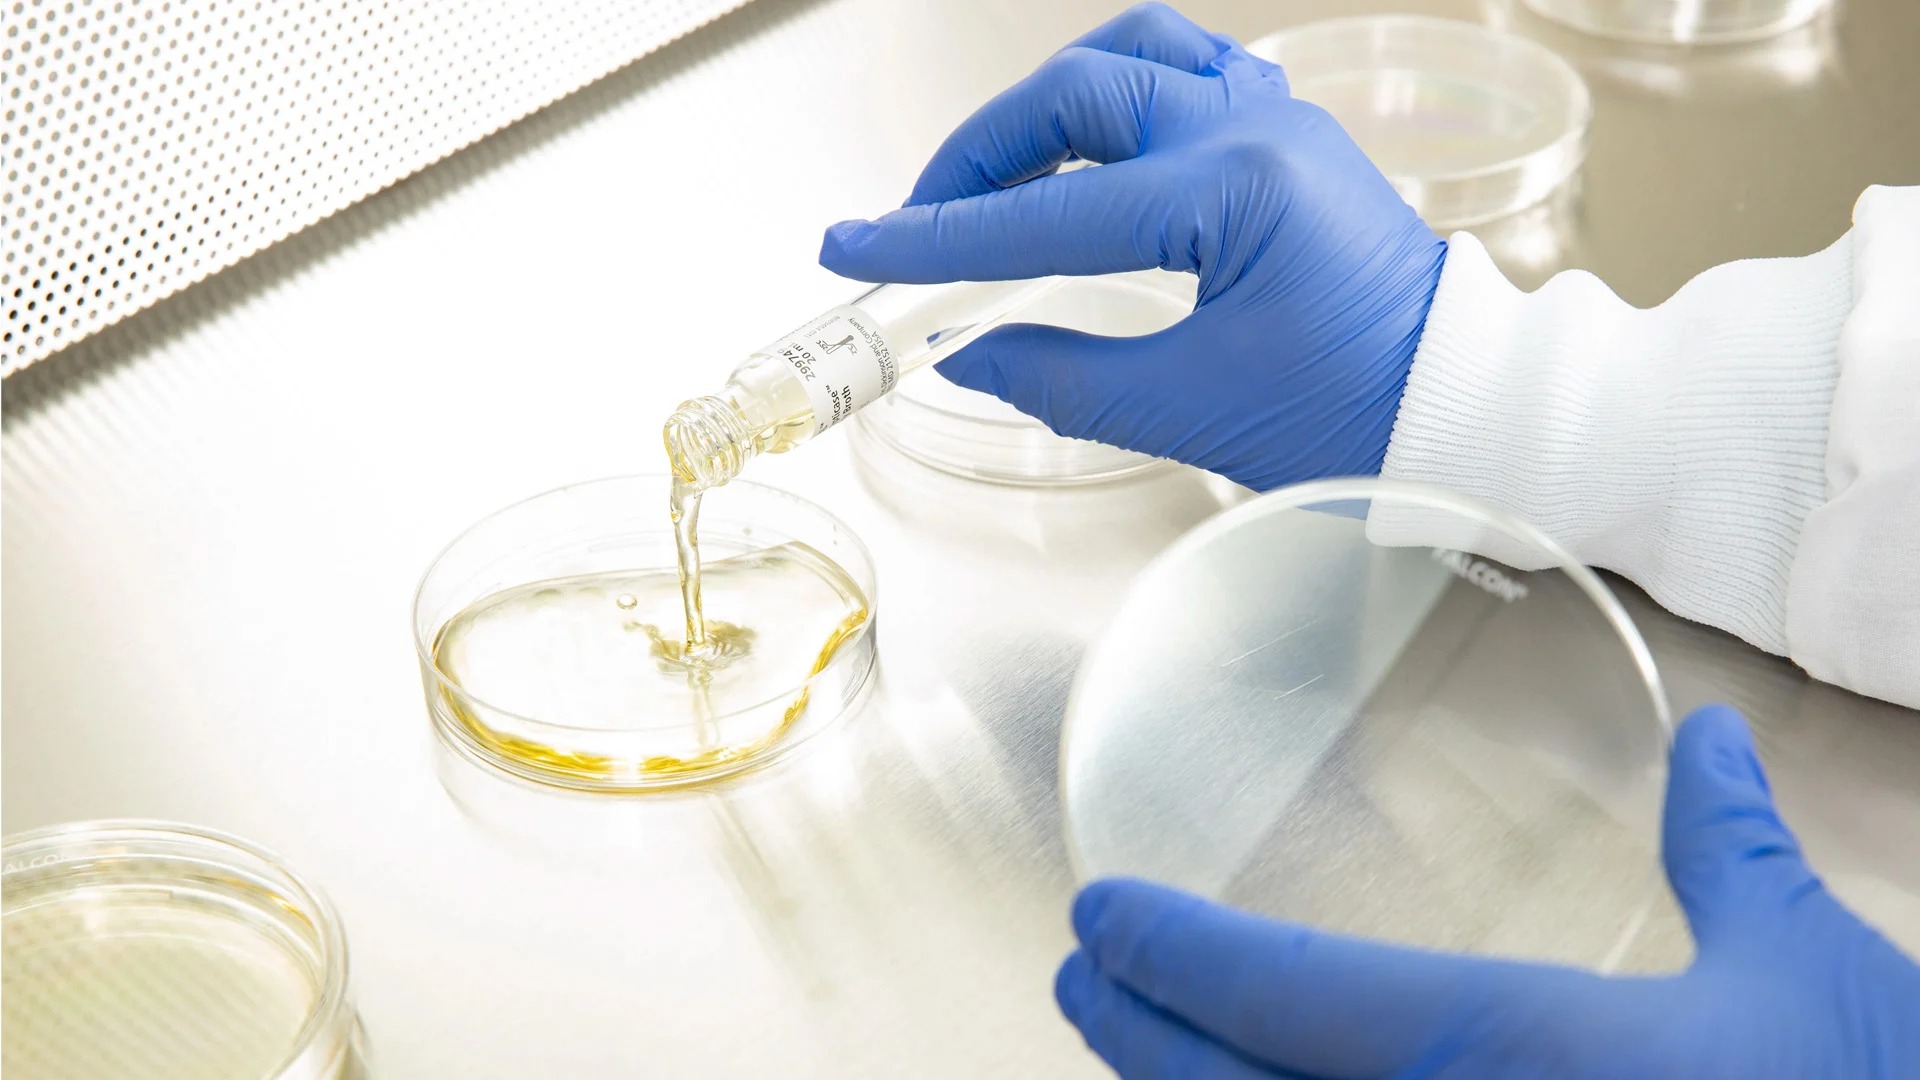
Environmental monitoring lab work

Programs designed on solid regulatory ground.
Environmental monitoring is where regulatory expectations and operational reality meet. A program that looks good on paper can fail inspection because the sampling strategy does not match the actual contamination risk. A program that works operationally can fail because the documentation does not defend the approach.
Every EM program we design runs with senior specialists who have sat through EU GMP Annex 1 and FDA inspections. Karina and Elsebeth know isolator environments from inside the cleanroom. The sampling plan, the trending logic, and the CAPA framework all come from people who have defended them live.
- Risk-based sampling strategy matched to your actual isolator environment
- EU GMP Annex 1 and FDA requirements built in from program design
- 483 remediation support when the inspection has already happened

Fixed-fee packages when the 483 has landed.
483 observations on EM gaps are crisis procurement. You need a defined scope, a defined timeline, and a defined cost — approved internally by end of the week, not after a month of scoping back-and-forth. We structure 483 remediation as 60-day fixed-fee packages with milestone gates you can present to leadership on day one.
Protocol development, execution oversight, CAPA documentation, and the inspection-ready package your regulator will read. Each phase has a signed acceptance. No hourly exposure. No scope creep during the period when every call and every email feels like an invoice.
- 60-day fixed-fee packages for 483 remediation and CAPA response
- Protocol development and execution oversight with milestone signoffs
- Inspection-ready documentation package delivered at close-out
Documentation that holds up.
The best EM documentation tells a story. Why this sampling plan, why these alert and action levels, why this trending interval, why this CAPA response. An auditor who reads a coherent decision trail stops asking questions. An auditor who reads a template starts digging.
Every engagement produces documentation your team owns and can defend. Decision rationale, trending frameworks, CAPA logic, and the inspection playbook for your QA team. The next audit reads continuity. Your next hire inherits a readable system. Nothing walks out the door with us.
- Decision rationale documented for each sampling and alert-level choice
- Trending frameworks and CAPA logic transferred to your QA team
- Inspection playbook your team can run the next audit from

Talk to our EM specialists.
Karina and Elsebeth know isolator environments. Whether you are designing a new program or responding to an observation, send us your brief and we come back within 24 hours with a scoped approach.
